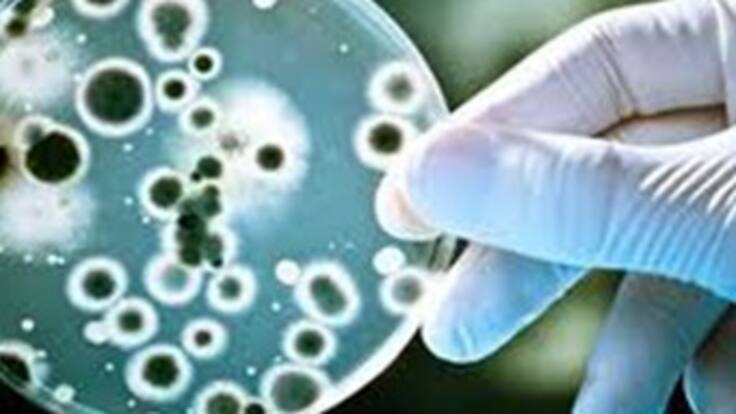
46 Festival de la leyenda vallenata

46 Festival de la leyenda vallenata
Este sábado de 10 a 12 de la noche, en Los Grandes Especiales de Caracol Radio, el profesor Arminio Mestra nos contara entre otros, la programación a realizarse en este festival, los sitios turísticos, los reyes vallenatos, su comida típica y la musica de los mejores intérpretes de este género. Si quiere escuchar los anteriores especiales puede entrar a: http://www.caracol.com.co/feed.aspx?id=PROG_562026.
46 Festival de la leyenda vallenata
El código iframe se ha copiado en el portapapeles
Este sábado de 10 a 12 de la noche, en Los Grandes Especiales de Caracol Radio, el profesor Arminio Mestra nos contara entre otros, la programación a realizarse en este festival, los sitios turísticos, los reyes vallenatos, su comida típica y la musica de los mejores intérpretes de este género. Si quiere escuchar los anteriores especiales puede entrar a: http://www.caracol.com.co/feed.aspx?id=PROG_562026




